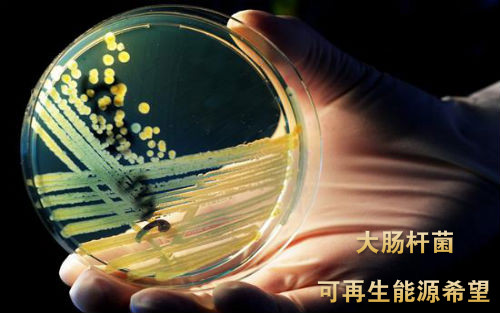

近日,发表在《自然通讯》杂志上的一项研究中,一组科学家大肠杆菌阻断了脂肪进入细胞膜的生物过程。研究人员通过一些酶阻断了大肠杆菌中脂肪酸进入细胞膜的生物过程,引导脂肪酸进入不同的生物途径,最终使大肠杆菌产生了可再生的丙烷。该研究为实现能源的可再生提供了可能性,有望取代不可再生的化石燃料。
化石燃料是一种有限资源,随着人口的不断增长,人类必须找到新的材料或技术来满足日益增长的能源需求。丙烷是液化石油气的主要组成部分,很容易液化,在合成后能够立刻被分离出来,易于运输、存储和使用。
在这项研究中,科学家们使用大肠杆菌作为宿主生物体,首先通过硫酯酶新的变体中断大肠杆菌脂肪酸进入生物膜的过程,得到了丙烷产生的前体化合物——丁酸。随后,他们用了一种叫做酰基载体蛋白质的细菌酶让丁酸变成丁醛。最后,他们用了一种最近才发现的能够催化丙烷生成的酶AOD(aldehyde-deformylating oxygenase)。虽然此前也有科学家尝试通过ADO产生燃料,但是结果都不尽人意。在这项研究中,科学家们通过电子刺激ADO,增强了它们的催化能力,最终产生了丙烷。
参与该研究的Patrik Jones博士说:“我们的研究为可再生能源的可持续生产提供了可能性。在初始阶段,细菌燃料可以作为一种补充能源,但最终会取代化石燃料,包括柴油、汽油、天然气等。”
不过,该研究目前还处于早期发展阶段,大肠杆菌产生的丙烷水平较低,科学家们正在改进合成过程。他们希望未来5-10年,该研究可以实现商业上的可行性。研究人员的最终目标是,将大肠杆菌的这个产能系统转入到光合细菌中,将来有一天可以将太阳能直接转化为化学能。







